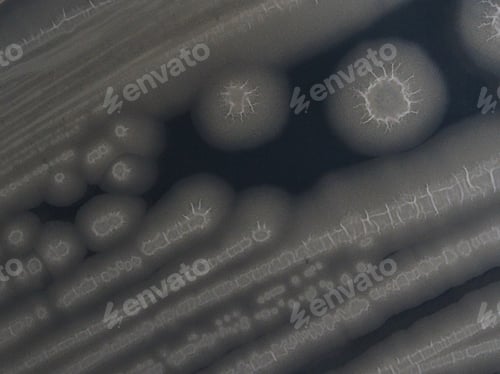
Preview: Colonies of Bacillus subtilis natto

Binary Code Royalty-Free Stock Photos
Browse our library and you will find many awesome royalty-free binary code stock photos, pictures and images. We are confident you will find the right one for your project!
How satisfied are you with your Photos experience today?

Binary Code
Binary Code Binary
Binary Code
Code Coding
Coding Digital Background
Digital Background Binary Code
Binary Code Ascii
Ascii Code
Code Coding
Coding Hacker
Hacker